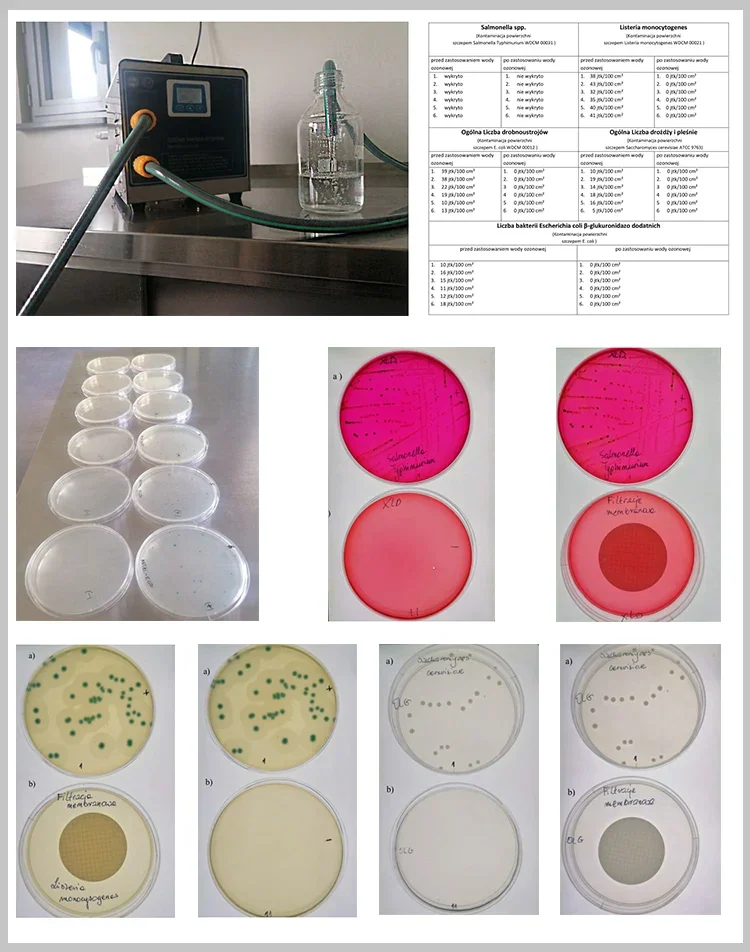
TLF Spa Ozon Wasser Generator Wäsche Ozon Generator Haus Ozon System

- Zuhause
- Bestseller
-
Alle Kategorien
- Alle Kategorien
- frauen Kleidung
- Herrenbekleidung
- Telefone u. Telekommunikation
- Computer & Office
- Unterhaltungselektronik
- schmuck & Zubehör
- Haus & Garten
- Gepäck u. Beutel
- Schuhe
- Haushaltsgeräte
- Motorrad ausrüstungen & teile
- Büro- & Schulartikel
- Auto & Motorrad
- Spielzeug
- Unterwäsche, Socken, Sleep & Lounge Tragen
- Armbanduhr
- Bücher und kulturelle Merchandise
- Geräte
- Test category 06
- Sport Schuhe, Kleidung & Zubehör
- Industrie & Wirtschaft
- Sport & Unterhaltung
- Hochzeiten & Events
- Nahrung
- Neuheit u. spezieller Gebrauch
- Schönheit u. Gesundheit
- Elektronische Bauteile & Waren
- Haar-Verlängerungen u. Perücken
- Mutter& kinder
- Licht & Beleuchtung
- Telefone und Telekommunikationszubehör
- Sicherheit & Schutz
- Hauptverbesserung
- bekleidung Zubehör
- newlv1categorytest
- Möbel
- Alle Geschäfte